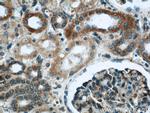
MRPL28 Antibody in Immunohistochemistry (Paraffin) (IHC (P))

Search
Proteintech
MRPL28 Polyclonal Antibody
{{$productOrderCtrl.translations['antibody.pdp.commerceCard.promotion.promotions']}}
{{$productOrderCtrl.translations['antibody.pdp.commerceCard.promotion.viewpromo']}}
{{$productOrderCtrl.translations['antibody.pdp.commerceCard.promotion.promocode']}}: {{promo.promoCode}} {{promo.promoTitle}} {{promo.promoDescription}}. {{$productOrderCtrl.translations['antibody.pdp.commerceCard.promotion.learnmore']}}

Please note: We are reviewing Western blot images included in the antibody testing data in our catalog, including those provided by third parties. Unless expressly labeled or annotated as “raw-unedited”, Western blot images included in the antibody testing data in our catalog may have been edited, optimized or otherwise adjusted for presentation.
产品信息
21604-1-AP
种属反应
宿主/亚型
分类
类型
抗原
偶联物
形式
浓度
规格
纯化类型
保存液
内含物
保存条件
运输条件
产品详细信息
Immunogen sequence: MPLHKYPVW LWKRLQLREG ICSRLPGYYL RSLEEERTPT PVHYRPHGAK FKINPKNGQR ERVEDVPIPI YFPPESQRGL WGGEGWILGQ IYANNDKLSK RLKKVWKPQL FEREFYSEIL DKKFTVTVTM RTLDLIDEAY GLDFYILKTP KEDLCSKFGM DLKRGMLLRL ARQDPQLHPE DPERRAAIYD KYKEFAIPEE EAEWVGLTLE EAIEKQRLLE EKDPVPLFKI YVAELIQQLQ QQALSEPAVV QKRASGQ (1-256 aa encoded by BC000990)
靶标信息
MRP-L28 (39S ribosomal protein L28, melanoma-associated antigen recognized by T lymphocytes) is a mitochondrial protein that belongs to the ribosomal protein L28P family. MRP-L28 potentially represents an important therapeutic reagent for HLA-A24 (A24) patients as this antigen is recognized by tumor-infiltrating lymphocyte (TIL) 1290, which targets the A24 serotype. HLAA24 (A24) is an HLA-A serotype that identifies the more common HLA-A24 gene products. A24 is a split antigen that is also recognized by the A9 broad antigen type and the similar A23 types. A24 is common in Austronesia and has one of the highest A allele frequencies for a number of peoples, including Papua New Guineans, indigeonous Taiwanese (eastern tribals), Yupik and Greenland Eskimos. MRP-L28 is found in a variety of normal tissues including spleen, testis, thymus, liver, kidney, brain, adrenal, lung and retinal tissue.
仅用于科研。不用于诊断过程。未经明确授权不得转售。
生物信息学
蛋白别名: 39S ribosomal protein L28, mitochondrial; HGNC6756; L28mt; Large ribosomal subunit protein bL28m; MAAT 1; Melanoma antigen p15; Melanoma-associated antigen recognized by T-lymphocytes; MGC8499; mitochondrial ribosomal protein L28; MRP L28; MRPL 28
基因别名: 1110015G04Rik; L28mt; MAAT1; MRP-L28; MRPL28; p15
UniProt ID: (Mouse) Q9D1B9
Entrez Gene ID: (Rat) 497876, (Mouse) 68611




